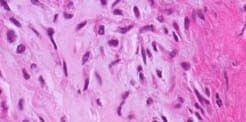

ULTIME NOTIZIE
OLTRE 10 MILIONI DI PERSONE IN TUTTO IL MONDO SONO INFETTATE DA PARASSITI. LEGGI FINO ALLA FINE DELL'ARTICOLO PER SCOPRIRE CHI È ESPOSTO AL PERICOLO!
Un italiano su due ospita parassiti all'interno del proprio corpo!
Il nostro programma ha ricevuto un enorme riscontro da parte del pubblico, che ci ha letteralmente inondato di messaggi e chiamate chiedendoci di raccontare come i vermi entrano nel nostro corpo! Così oggi abbiamo invitato in studio il parassitologo №1 in Italia, il dott. Lorenzo Ascaridi.
Vi diremo anche quali sono i cibi da controllare attentamente e quali è meglio non acquistare.

Stando all'Istituto di Parassitologia, la presenza dei parassiti nel corpo porta a un gran numero di malattie, cominciando con i raffreddori e terminando con ulcere e tumori. Dott Ascaridi, può dirci quanto sono precisi i dati dell'Istituto e se possiamo fidarci?
Naturalmente. Mi fido delle nostre statistiche al cento per cento. Gli studi che abbiamo effettuato erano molto accurati. Oltre il 91% dei decessi si verifica a causa dei parassiti . Perfino i casi di "morte naturale" sono causati da queste vili creature.
Lei ha visitato personalmente i nostri volontari. Possiamo svelare i risultati?
Diamo per esempio un'occhiata alle condizioni di conservazione del pesce, della carne, della frutta e della verdura che vengono spesso immagazzinati a una temperatura troppo alta, riutilizzando lo stesso contenitore. Poi, la muffa viene eliminata e il cibo, di fatto vecchio, e viene venduto come fresco.
La nostra redazione ha condotto uno studio indipendente e controllato le condizioni di conservazione degli alimenti che compriamo ogni giorno. Abbiamo fatto degli scatti unici, in questo modo potrete giudicare da voi la qualità del cibo che consumate.






Ci spieghi, per favore, come l'infestazione provoca malattie mortali.
Non parlerò di tutti i casi che abbiamo diagnosticato, mi concentrerò invece su quelli che probabilmente sono i più terribili e comprensibili. Alcuni vermi, come i cestodi, possono provocare cancro . In questo caso, i vermi stessi possono contrarre la malattia e le loro cellule tumorali maligne "invadono" gli esseri umani.
E ora elencherò i sintomi in modo tale che possiate determinare se ne siete affetti o no. Se avete notato nervosismo frequente, eccessiva irritabilità e sbalzi d'umore, è probabile che i parassiti siano già penetrati nel vostro cervello, dove si moltiplicano, crescono e si diffondono provocando un tumore. Ecco qui alcune immagini del cervello di pazienti deceduti.


E non si tratta di casi rari.
Qui ce ne sono di più. Si ritiene che la filaria sia rara, ma in realtà vive nel 25% della popolazione. Pensateci, si tratta di una persona su quattro. Se parliamo di morte improvvisa provocata da un arresto cardiaco, i parassiti ne sono la causa nel 60% dei casi.

Ed ecco qui alcuni esempi di parassiti intestinali. Questi pazienti hanno dovuto rimuovere quasi completamente gli organi danneggiati . Naturalmente nessuno di loro è sopravvissuto.


2. Aumento di letargia e apatia
3. Occhiaie e borse sotto gli occhi
4. Raffreddori frequenti
5. Allergie
6. Mal di testa frequenti
7. Costipazione o diarrea
8. Dolore muscolare e articolare
9. Disturbi del sonno e dell'appetito
Dottor Ascaridi, potrebbe dirci quali sono i parassiti più comuni in Italia?
Ascaridi: ogni anno questi vermi bianchi colpiscono oltre 2 milioni di persone. Entrano negli organi umani attraverso il cibo (di solito verdure, frutti ed erbe), l'acqua di rubinetto non bollita o depurata, la polvere e le mani sporche e spesso vengono trasportati dalle mosche.

Tenia del pesce: grandi creature longeve; la lunghezza di un singolo individuo può raggiungere i 10 metri e vivere nel corpo umano fino a 25 anni. Possono essere ingerite con il cibo o entrare attraverso la pelle, per esempio quando si cammina scalzi e tramite il contatto con gli animali. È molto difficile sbarazzarsene.

Questo vuol dire che non esistono farmaci in grado di aiutarci a eliminare i vermi all'interno dei nostri organi?
Si chiama Paraxan. L'abbiamo testato su dei volontari e nel 98% dei casi ha avuto successo. Basta un trattamento di 3 settimane per ripulire l'organismo da qualsiasi tipo di parassita! Oggigiorno è l'unico modo efficace che esiste sul pianeta per eliminare i vermi dal corpo.
- Paraxan distrugge ed elimina i parassiti annidati in qualsiasi parte del corpo: dal cervello al cuore, dal fegato all'intestino. Inoltre, non si tratta di un farmaco a base di sostanze chimiche, bensì di un prodotto completamente naturale che non causa reazioni allergiche, squilibri intestinali né altri problemi.

